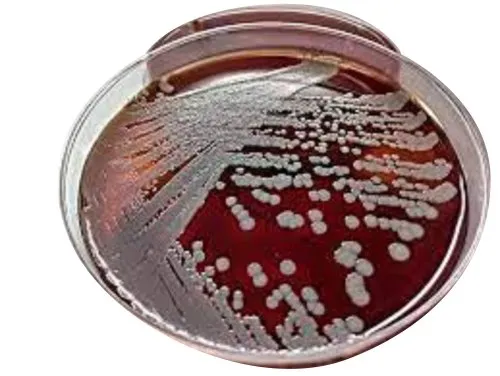

Scigenta Biosciences LLP
Established in the year 2021 in Bengaluru, Karnataka, We “Scigenta Biosciences LLP” are an acknowledged organization and are Limited Liability Partnership firm, engaged as a Manufacturer of Agar Plate, Agar Sheep Blood and many more.
SciGenta Biosciences is Preclinical CRO, offering an array of Preclinical Services in-vivo and in-vitro for screening and evaluating new drugs and formulations for early drug discovery and development. Our services include Efficacy studies, Pharmacokinetic (PK) assessments, Exploratory Toxicology as well as Microbiology and Cell biology. We also offer a full biocompatibility testing program for medical devices.
Preview
01, New No. 49, 2nd Floor, 1st Main Road, M S Ramaiah Enclave,,Opp Anugraha Bakery, Urban, Begalakunte,,
Bengaluru - 560073
Bengaluru - 560073
Contact Details

Columbia Agar 5% Sheep Blood
Usage/Application Laboratory
Physical State Liquid
Category Simple Media
Grade Standard Bio-Tech Grade
Sodium Chloride 5.0 g
Corn Starch 1.0 g
Plate Diameter 100mm
Agar 13.5 g
Storage Temperature 35 DegreeC
Sheep Blood(Defibrinated) 5 %
Specification/Additional Details
Usage/ApplicationLaboratory
Physical StateLiquid
CategorySimple Media
Grade StandardBio-Tech Grade
Agar13.5 g
Plate Diameter100mm
Bengaluru - Karnataka